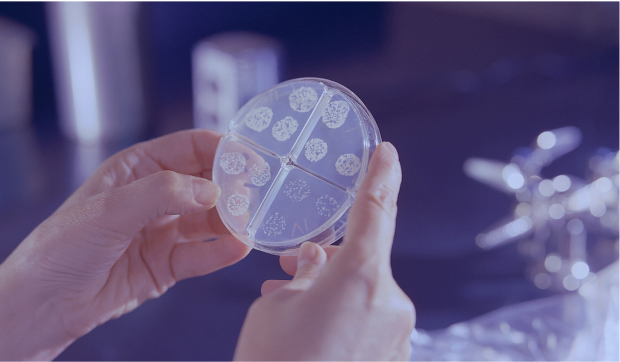

Science &TEchnology
Innovating on the journey to de-extinction.
Arriving at the resurrection of the woolly mammoth is a progression of systems. One building on top of the other to achieve a goal. From genetics to software engineering, embryology, the exogenous development of fetuses, animal husbandry and conservation, Colossal is innovating new technologies and solutions every step of the way.
System reboot
DE-EXTINCTION,
A Systems Solution
Our story is analogous to that of NASA’s Apollo mission. Astronauts did not just appear on the moon. Hundreds, if not thousands, of new technologies were developed to build the systems needed to get to the moon. The same can be said for our mission to de-extinction.
And as we innovate, invent and develop for the purpose of de-extinction, at some point our discoveries will translate into commercial applications with long-lasting benefits for our planet at large and all species - including our own.

THE 4 STEPS TO
COMMERCIAL EVOLUTION
De-Extinction
Where it all starts and ends. Protecting the future by reviving the past. A goal achievable through discovery and invention.
Software /
Wetware / Hardware /
Arriving at de-extinction requires the development of many ancillary and independent systems. Some digital, some physical.
Technologies /
IP Creation
Many of these developments will be patentable and provide valuable function for a variety of biological and day-to-day uses.
Commercialization
Much like the Apollo mission led to modern day mobile phones, our de-extinction discoveries will lead to a commercial evolution.

PROGRAMMING
A BETTER
TOMORROW
Improving Biodiversity Through Modern Technology.
Throughout the course of our mission, Colossal is continually pioneering revolutionary software, wetware and hardware solutions. With each new innovation, we uncover answers to some of Earth’s most critical problems.

These breakthroughs in biotechnology have applications both in and beyond our labs. As is true of all things with great off-label uses, Colossal’s discoveries will create and inspire new opportunities that extend far beyond de-extinction. As was the case with Apollo, we fully intend that what we discover and develop will create rippling effects for the next millennia of human advancement.
All
Systems
Go


At Colossal, our efforts are catalyzing software, wetware and hardware breakthroughs with applications and added value across a variety of methods and industries. This model, however, is not the first.
Visit the Labs Pageto See More
HOUSTON, WE HAVE A SOLUTION.
Ours is not the first groundbreaking endeavor to engineer complex systems in pursuit of a greater purpose.
The revolutionaries at NASA laid the groundwork. And eventually, one small step after the other landed with a giant leap.






Shaping The Future
Named after the Greek god of the Sun, the Apollo missions put a man on the moon. Making a total of 11 space flights, the Apollo program was certainly among NASA’s most well-equipped.
Naturally, a lunar landing called for science and technology that didn’t yet exist. However, undeterred by global cynicism, scientists created niche systems and devices to aid their mission. And in the process, these seemingly-singular creations led to the development of countless spin-off innovations. Many of which have worked their way in modern day-to-day life. Chances are you wouldn’t be able to read this webpage without the Apollo mission’s discoveries.
NASA has documented more than 2,000 spinoff technologies since the beginning of their annual commercialization publication.

In the event of a launch pad emergency, Kennedy Space Center’s emergency rescue personnel must crawl through a 20-inch square opening, sometimes saturated with toxic fumes. Thus, NASA developed the Supercritical Air Mobility Pack (SCAMP), a self-contained breathing apparatus (SCBA). The use of supercritical cryogenic air in SCAMP SCBA came from the technology developed for the life support fuel cell support systems for use in microgravity environments and is now used in ground-based applications, such as those in the emergency services industry.

Navigating astronauts safely through space and ensuring constant communication between the crew and ground control was paramount. As a result, NASA was a pioneer in developing cutting-edge wireless technology that enabled clear, consistent and long-range communication. NASA’s wireless technologies laid the foundation for today's wireless data communication systems, transforming industries from telecommunications to personal computing.

Spacecraft environments require precise temperature control to protect astronauts and onboard equipment from the extreme heat of takeoff and extremely cold environment in space. The advanced heating and cooling systems developed for the Apollo missions have influenced modern HVAC technologies, not only keeping our homes comfortable but conserving energy, as well.

Following the tragic Apollo 1 cabin fire, NASA felt it necessary to redesign the mission’s spacesuits for future crew members. To make the suits fire-resistant, NASA scientists formulated a material that was durable, strong, lightweight, flexible and non-combustible — fiberglass fabric coated with Teflon. Today, this fabric is widely-used in architecture and can be found all over the world, particularly atop U.S. stadiums.

NASA’s expertise in sound and vibration sensing technology, initially developed for spacecraft instrumentation, contributed to the development of cochlear implants. These devices now help thousands around the world by restoring a sense of hearing to those with profound hearing loss.

To simulate conditions in space, NASA created robotics and materials that mimicked the movement and adaptability of human limbs. This technology was later adapted to enhance the development of more dynamic, durable, and responsive artificial limbs, offering mobility and hope to countless amputees.

To aid in the autonomous rendezvous and docking of space vehicles to satellites, NASA created and equipped spacecraft with advanced target-tracking technology. This technology led to the development of precision tracking systems capable of measuring movement with unparalleled accuracy. Soon after, NASA’s technology became pivotal in ophthalmology—aiding in the development of LASIK surgery, where surgeons needed to make precise cuts on the cornea without error. What began as a means to assist response time in space now serves as a cornerstone in providing millions with clearer vision on Earth.

In preparation of the Apollo missions, many of which lasted up to 13 days, NASA conducted extensive research into longer-lasting space food. To ensure that astronauts’ rations would remain well-preserved and safe to eat, NASA created better ways to package the food itself: freeze-drying and vacuum-sealing. These methods were quickly commercialized, ultimately becoming the industry standard in quality control.

While water is a limited resource on Earth, it’s even more sacred in space. NASA's development of advanced water purification and filtration systems made it possible to recycle and purify water for astronauts aboard the Apollo missions. Today, this technology provides clean drinking water to billions of people on Earth.

Harnessing the sun's energy in space was crucial for sustained space travel, especially the nearly two-week Apollo missions. NASA's development of solar panel technology—originally used to power equipment onboard Apollo spacecraft—has had a lasting impact, leading to the widespread use of solar panels as a sustainable energy source for today’s homes and businesses.

NASA's intricate sensors and monitoring systems were originally designed to track astronauts' health in space. However, they spurred advancements in many of the medical device technologies we use today. NASA’s medical innovations—such as thermometers, electrocardiogram electrodes, X-ray imaging and more—now underpin various diagnostic tools and monitoring devices that enhance patient care on a global scale.

Aiming for optimal safety and comfort, NASA-funded researchers needed new ways to keep test pilots cushioned during flights. Hence, they developed a dense, pressure-tolerant, shock-absorbing memory foam, otherwise known as temper padding. Today, the material is known commercially as TEMPUR foam and has revolutionized products like mattresses, seating and shoe sole inserts—providing unparalleled comfort to millions.

During the Apollo Program, astronauts on the Moon encountered several problems when dealing with lunar dust. In addition to being rich in ultraviolet radiation, lunar dust sticks to spacesuits, spacecraft, tools and equipment—and is extremely difficult to remove. NASA's research into Apollo-era communication and radar technology led to the development of microwave technology that could heat lunar soil to temperatures high enough to solidify the surface. What began as a critical evolution in design and capability for space travel paved the way for a range of applications, including the one commonly used in modern-day kitchens.

Preparing for the unknowns of space, NASA conducted rigorous studies on medications, their storage and their effects in a zero-gravity environment. This research, performed by Apollo astronauts, provided valuable insights that shaped pharmaceutical practices and innovations, such as synthetic biology, 3D printing and new-age drug delivery systems on Earth.

The harsh conditions of space required specialized protection for craft, crew and equipment. However, conventional metal lubrication processes were inadequate for the lightweight materials used in Apollo components. In order to shield spacecraft and equipment, NASA partnered with General Magnaplate to develop techniques that bond dry lubricant coatings to space metals. These coatings were impervious to outgassing, had enhanced surface hardness and offered superior resistance to corrosion and wear. General Magnaplate went on to advance the technology, eventually becoming a leader in high-performance surface enhancement coatings used in everything from pizza making to laser manufacturing.

[ QUOTE ]
“NASA licenses space-age technologies for the creation of products that improve lives here on Earth.”
Excerpt from a 2004 NASA Press Release,
Lyndon B. Johnson Space Center
A
Colossal
Leap For
Mankind
Like the Apollo program, the scientific efforts at Colossal make ongoing contributions to the scientific community. Today, we too are within reach of another massive scientific breakthrough, one that will create a positive impact on the long-term health of Earth and its inhabitants, both past and present, as we look forward to rewilding the future.
“We choose to go to the moon in this decade and do the
other things, not because they are easy, but because they
are hard.”
- John F. Kennedy
+
+
TECHNOLOGIES &
SYSTEMS OF
DE-EXTINCTION

A Closer Examination of Colossal’s Fields
of Study.
At Colossal Biosciences, our pursuit of a better, stronger, more biodiverse future encompasses a wide range of foci. By delving deep into these fields and innovating within, we unravel the mysteries of life and unlock limitless possibilities and commercially-viable mechanisms.

The focus areas of our system
Our interdisciplinary approach enables us to make significant strides in the following key areas:

GENETIC
ENGINEERING
01
Genetic engineering and genome editing allows our team to precisely modify the genetic material of organisms, opening up avenues for
Embryology +

Stem Cell
Reprogramming


05
CONSERVATION
& ANIMAL
HUSBANDRY

06
EXOGENOUS
DEVELOPMENT
De-Extinction requires the sum of
these parts
GENETIC ENGINEERING
Genetic engineering and genome editing allows our team to precisely modify the genetic material of organisms, opening up avenues for
AI & MACHINE LEARNING
Colossal's utilization of Artificial Intelligence and Machine Learning technologies empower us to extract valuable insights from complex biological data. By developing advanced algorithms and computational models, we uncover patterns, make predictions and accelerate scientific discoveries in areas such as:
EMBRYOLOGY
Advancements in embryology provide critical insights into early development, thus enabling us to understand the intricate processes that shape life. This knowledge has implications for:
STEM CELL REPROGRAMMING
Colossal explores the transformative potential of stem cell reprogramming, enabling the conversion of specialized cells into pluripotent stem cells. This breakthrough in technology has implications for:
CONSERVATION & ANIMAL HUSBANDRY
By optimizing breeding strategies and genetic selection, we enhance animal welfare, productivity and the conservation of threatened and endangered species, such as the:
EXOGENOUS DEVELOPMENT
By definition, exogenous development is the investigation of external factors and environmental cues that influence the growth and development of organisms. Understanding exogenous factors provide insights into:

Co-Founder / George Church, PH. D
The Science of
George Church
COLOSSAL POTENTIAL.
COLOSSAL IMPACT.
Our team’s unprecedented experimentations are paving the way for transformative spin-offs
that will soon reshape pedagogical methods, sharpen industries and improve conditions for
existence today, and in the future.

PRECISION
LIVESTOCK
SOLUTIONS
Leveraging Colossal's advancements in animal husbandry and genetic engineering, precision livestock farming techniques have emerged, enabling farmers to optimize animal health, welfare, and productivity through data-driven decision-making.

ENVIRONMENTAL REMEDIATION
Colossal's research in genetic engineering has enabled the development of plants and organisms with enhanced capabilities to remediate polluted environments. These engineered organisms have the potential to remove contaminants from soil, water, and air, aiding in environmental cleanup efforts.

BARCODE
MULTIPLEXING
Leveraging our expertise in genome editing, we have revolutionized the field of DNA barcoding with our cutting-edge barcode multiplexing technology. This breakthrough allows for the simultaneous identification of multiple genetic markers, enabling faster and more efficient analysis in diverse applications, from biodiversity studies to forensics.

SUSTAINABLE
AGRICULTURE
PRACTICES
Colossal's innovations in genome editing have paved the way for crop modifications that enhance resistance to pests, diseases, and environmental stressors. These advancements contribute to sustainable agriculture practices, reducing the reliance on pesticides and improving crop yields.

DISEASE
MODELING
Colossal's application of genome editing techniques, such as CRISPR-Cas9, has led to the creation of accurate disease models in animals and cell cultures. These models are instrumental in understanding disease mechanisms, testing potential treatments, and advancing precision medicine.
PLASTIC-EATING
BACTERIA
Colossal's expertise in genetic engineering has led to the development of bacteria capable of breaking down and consuming plastic waste, offering a potential solution to the global plastic pollution crisis.

BIOMEDICAL
DEVICES
Our commitment to pushing the boundaries of wetware technologies has led to the creation of innovative biomedical devices that revolutionize healthcare. From advanced biosensors for early disease detection to implantable devices for personalized medicine, these cutting-edge technologies are improving patient outcomes and transforming the way we deliver healthcare.

BIOINFORMATICS
Colossal's collaborations and advancements in genome analysis have contributed to significant breakthroughs in bioinformatics. This includes the development of sophisticated algorithms and tools for processing and interpreting large-scale biological data, revolutionizing the field of genomics.

REGENERATIVE
MEDICINE
Colossal's progress in embryology and in vitro fertilization (IVF) has provided critical insights and technologies that have expanded the field of regenerative medicine. This includes advancements in tissue engineering, stem cell research, and organ transplantation.
BUILDING TOMORROW TOGETHER
Colossal’s commitment to a safer, healthier planet extend beyond the walls of our lab. In fact, the positive impacts of spinoff innovations—born from our own groundbreaking science and technological advancements—are already underway. Through the continued pursuit of novel discoveries and a deeper understanding of our world, Colossal is helping build companies that share our vision for a brighter future.
Together, Colossal and spinoff companies like those listed below will continue to improve conditions on Earth for life today, tomorrow and years to come.

Colossal’s most
recent commercial
innovation.





+ A Colossal Innovation
Co-founded by Colossal, FormBio is evidence of our first commercialization success story. The first of many. Poised to transform the world of scientific collaboration—and equipped with an unwavering commitment to environmental responsibility—FormBio is an innovative solution that combines cutting-edge biotechnology with design to usher in a new era of discovery.
THE SHAPE, FORM AND FUTURE OF INNOVATION
Building upon our AI and machine learning prowess, we have co-founded FormBio, a revolutionary platform that utilizes advanced algorithms to accelerate the discovery and development of novel therapeutics. By analyzing vast amounts of data and predicting molecular properties, FormBio is transforming the drug discovery process, bringing us closer to life-saving treatments.
Lean More AboutForm Bio

Fighting Plastic
Waste and
MicroPlatics



Putting an end to the Plasticene Era.
Using the power of synthetic biology, microbial engineering and innovative Colossal technologies, Breaking is at the forefront of humanity's battle against plastic pollution. By identifying and evolving microbes that can convert plastic into harmless natural substances—like carbon dioxide, water and organic matter—bioscience is once again pioneering a sustainable solution to a manmade ecological crisis.



Empowering biology to eliminate
plastic waste.
Breaking is not just addressing a global threat to our future. It is actively building a better one by ensuring a cleaner, healthier planet for all its inhabitants.

TOMORROW:
JUST THE BEGINNING
THE FUTURE IS BIODIVERSE
In the pursuit of a better, healthier, more biodiverse Earth, Colossal will continue to make notable strides in the fields of science and technology. Our unwavering commitment to de-extinction and exploration has propelled us towards groundbreaking discoveries, revolutionizing multiple industries along the way.









